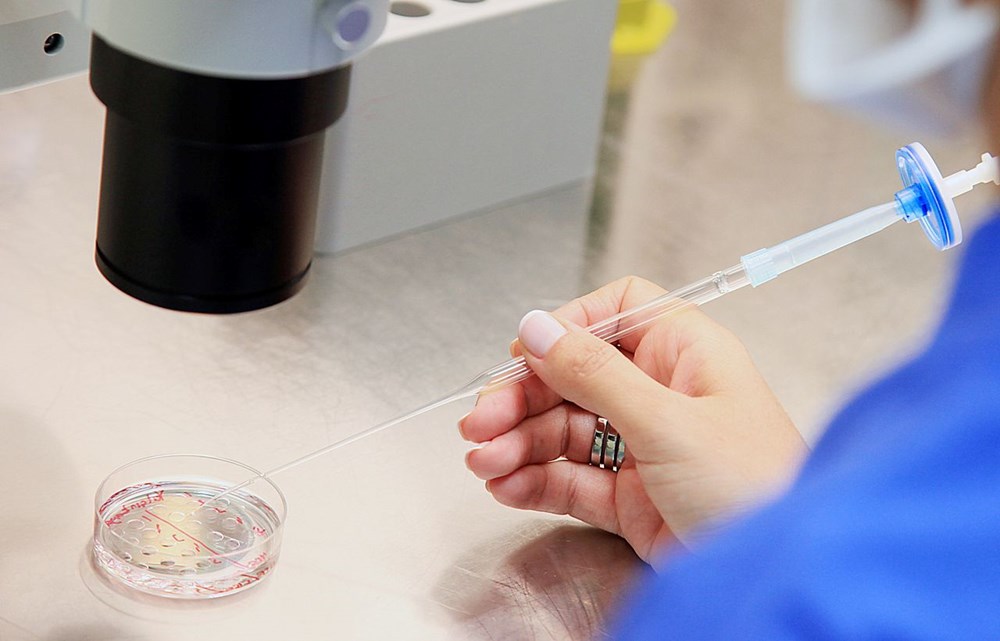
Dünyanın birinci sperm nakli: İhtilal niteliğinde bir tedavi olabilir 77 4XIKUrDq00myJFipkTvLbA

Jaiwen Hsu, çocuk sahibi olmasını engelleyen azospermi hastalığına sahipti. Araştırmalar, azosperminin dünya genelindeki erkeklerin yaklaşık yüzde birini etkilediğini ortaya koyuyor.

Azospermi, çoğunlukla hormonal bozukluklar, üreme sistemindeki tıkanıklıklar yahut genetik faktörlerden kaynaklanıyor. Jaiwen’in kısırlığının nedeni ise çocukluk periyodunda kemik kanseri tedavisi için aldığı kemoterapiydi; bu tedavi, üreme sistemini önemli halde etkilemişti.

Yapılan klinik deneyde, Jaiwen’in daha genç yaşlarda toplanıp dondurulmuş kök hücrelerinden yararlanıldı. Doğuştan testislerde bulunan sperm oluşturan kök hücreler, tekrar hastaya verilerek üreme sistemine nakledildi.

Pittsburgh Üniversitesi Tıp Merkezi’nde misyonlu tabipler, küçük bir iğneyi skrotumun tabanındaki rete testis ismi verilen testis kısmına yönlendirebilmek için ultrason kullandılar. Bu süreç, ergenlik periyodunda gerçekleşen doğal süreci taklit etmeyi amaçlıyor. Nakil başarılı olursa, Jaiwen’in sperm üretmeye başlaması bekleniyor.

Henüz menisinde sperm tespit edilmese de, uzmanlar sürecin testis dokusuna ziyan vermediğini doğruladı. Bilim insanları, sperm hücrelerinin gelişip gelişmediğini görmek emeliyle yılda iki defa sperm örneği almayı planlıyor.
Birçok doktor, bu işlemi umut verici bir gelişme olarak kıymetlendiriyor. Dr. Justin Houman, “Eğer bu teknik geliştirilip güvenliği kanıtlanırsa, spermatogonial kök hücre nakli, sperm üretme yeteneğini kaybetmiş erkekler için ihtilal niteliğinde bir tedavi olabilir” dedi.
Şimdiye kadar sırf hayvanlar üzerinde denenen bu metot, erkek fareler ve maymunların baba olmasına imkan tanımıştı.








